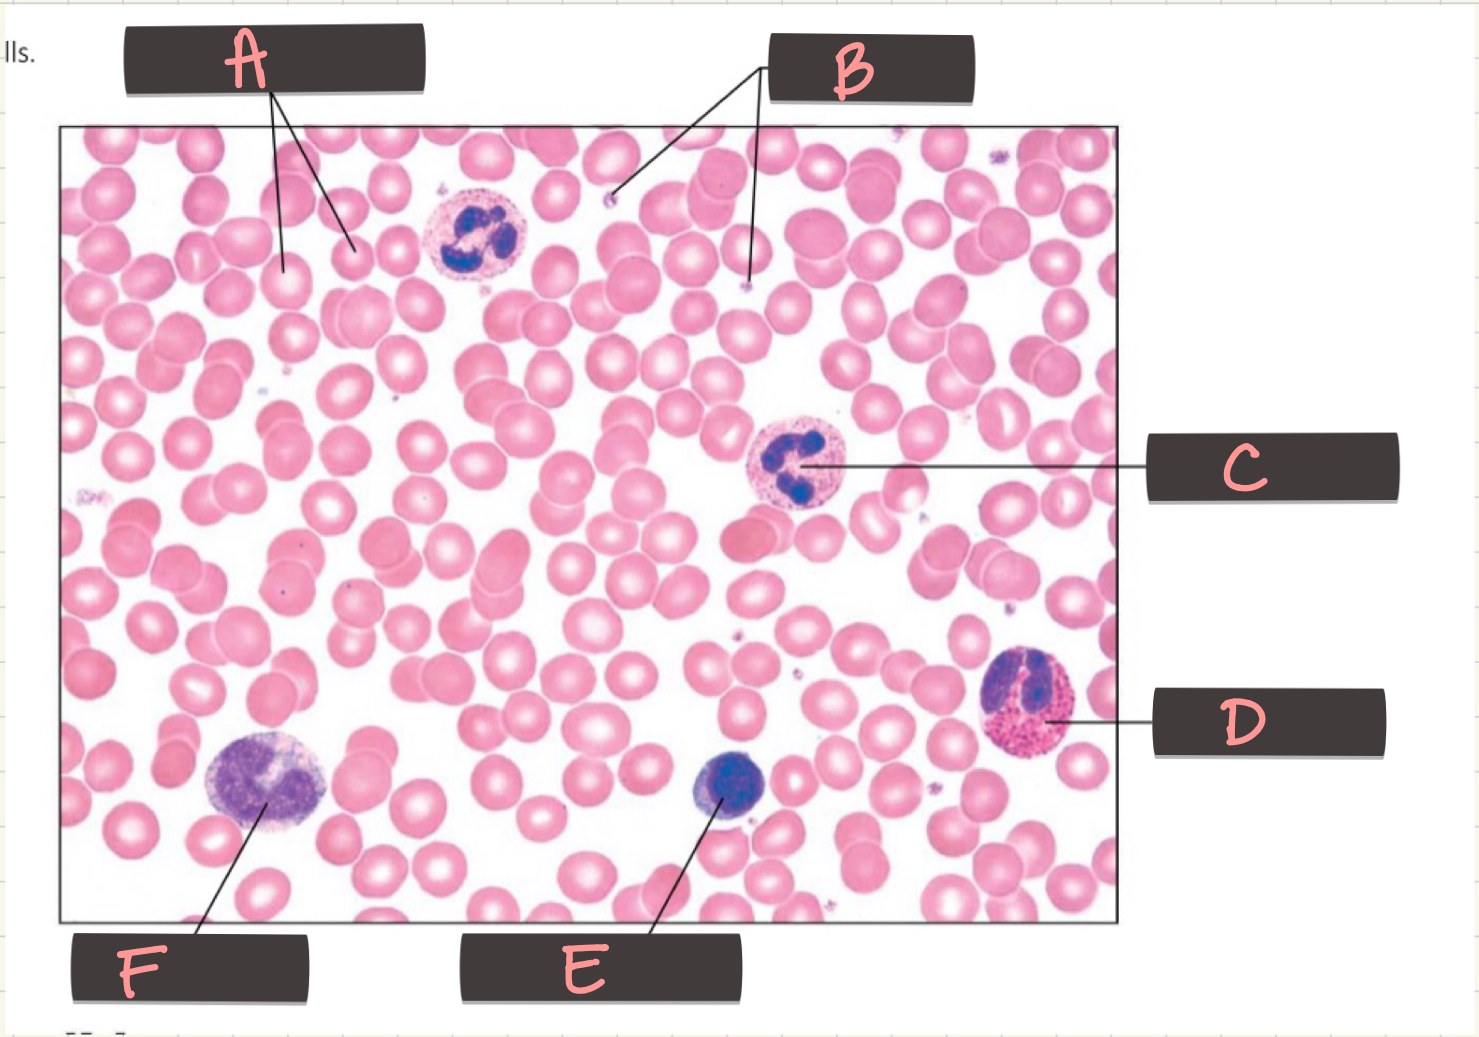
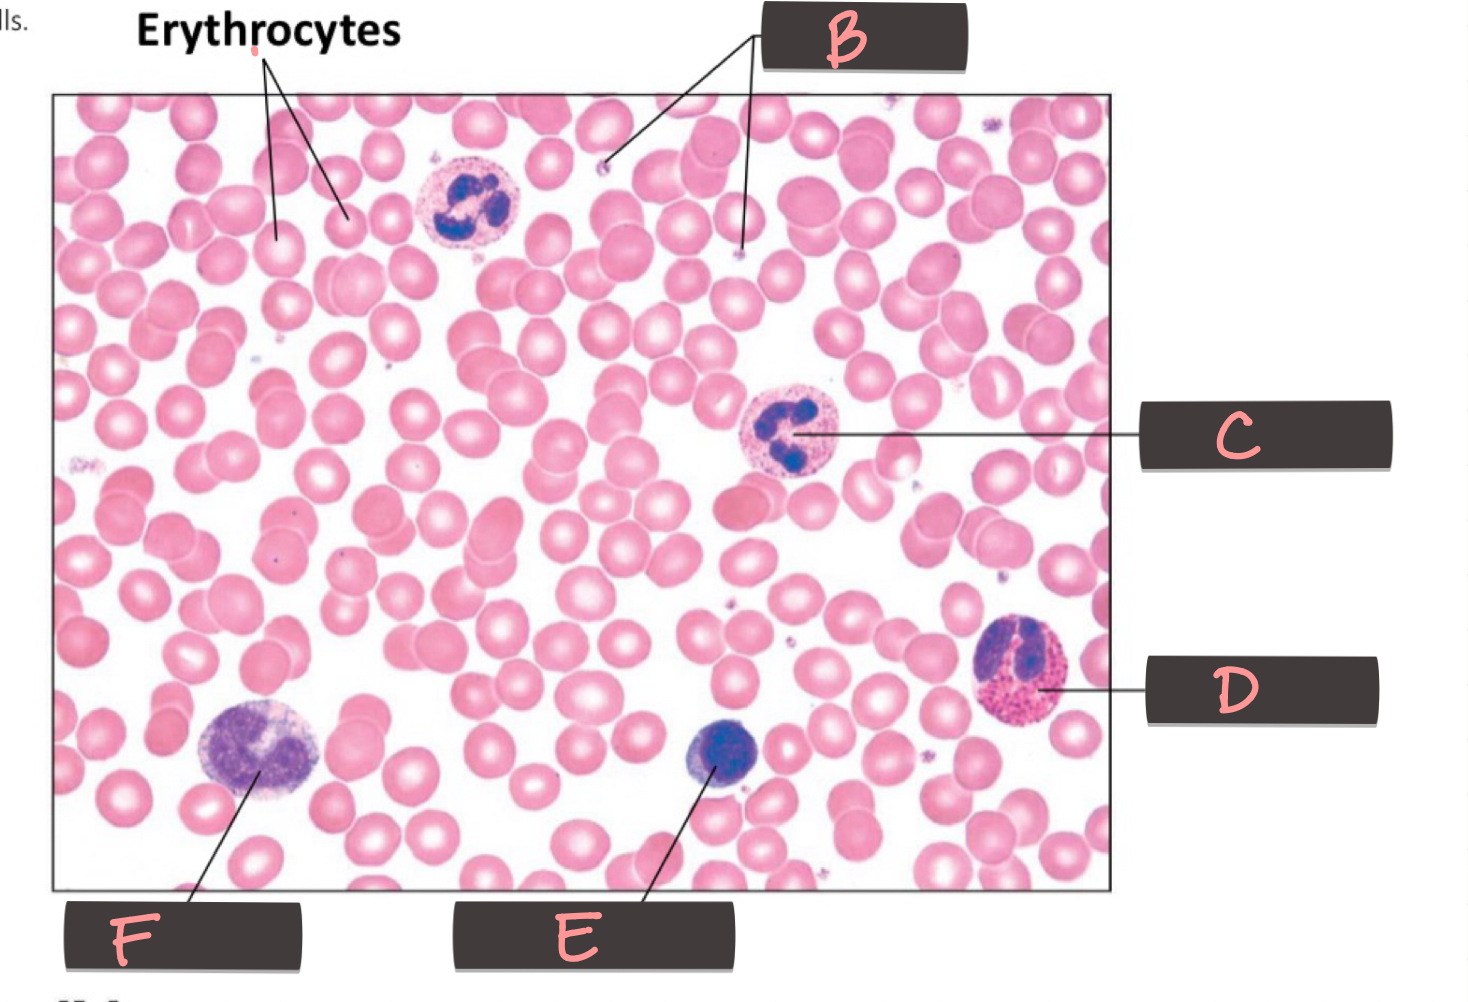
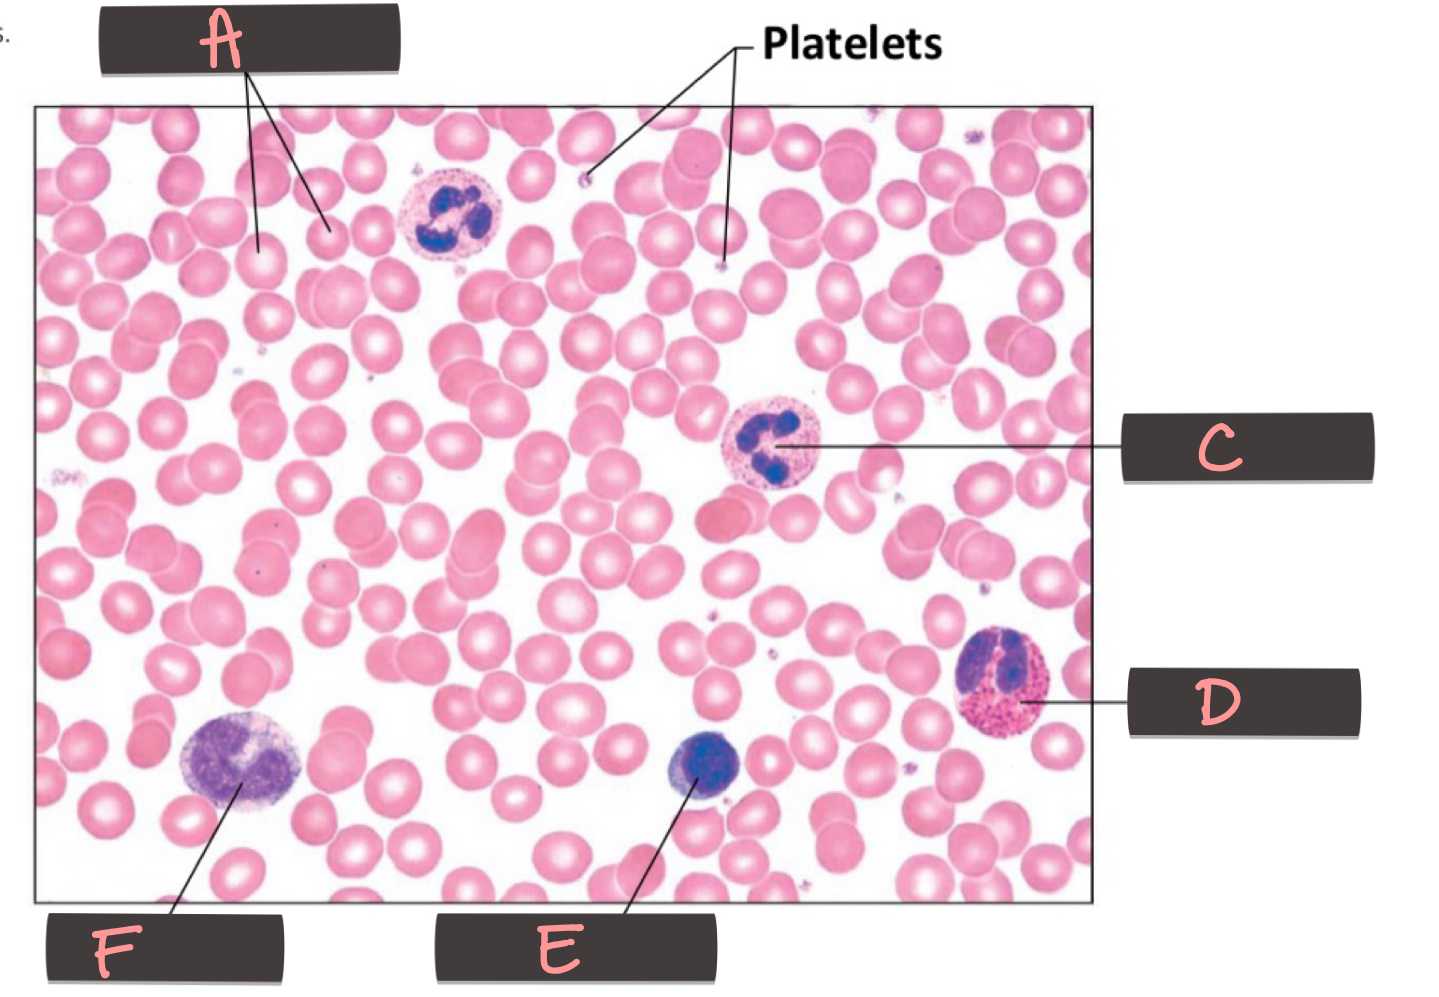
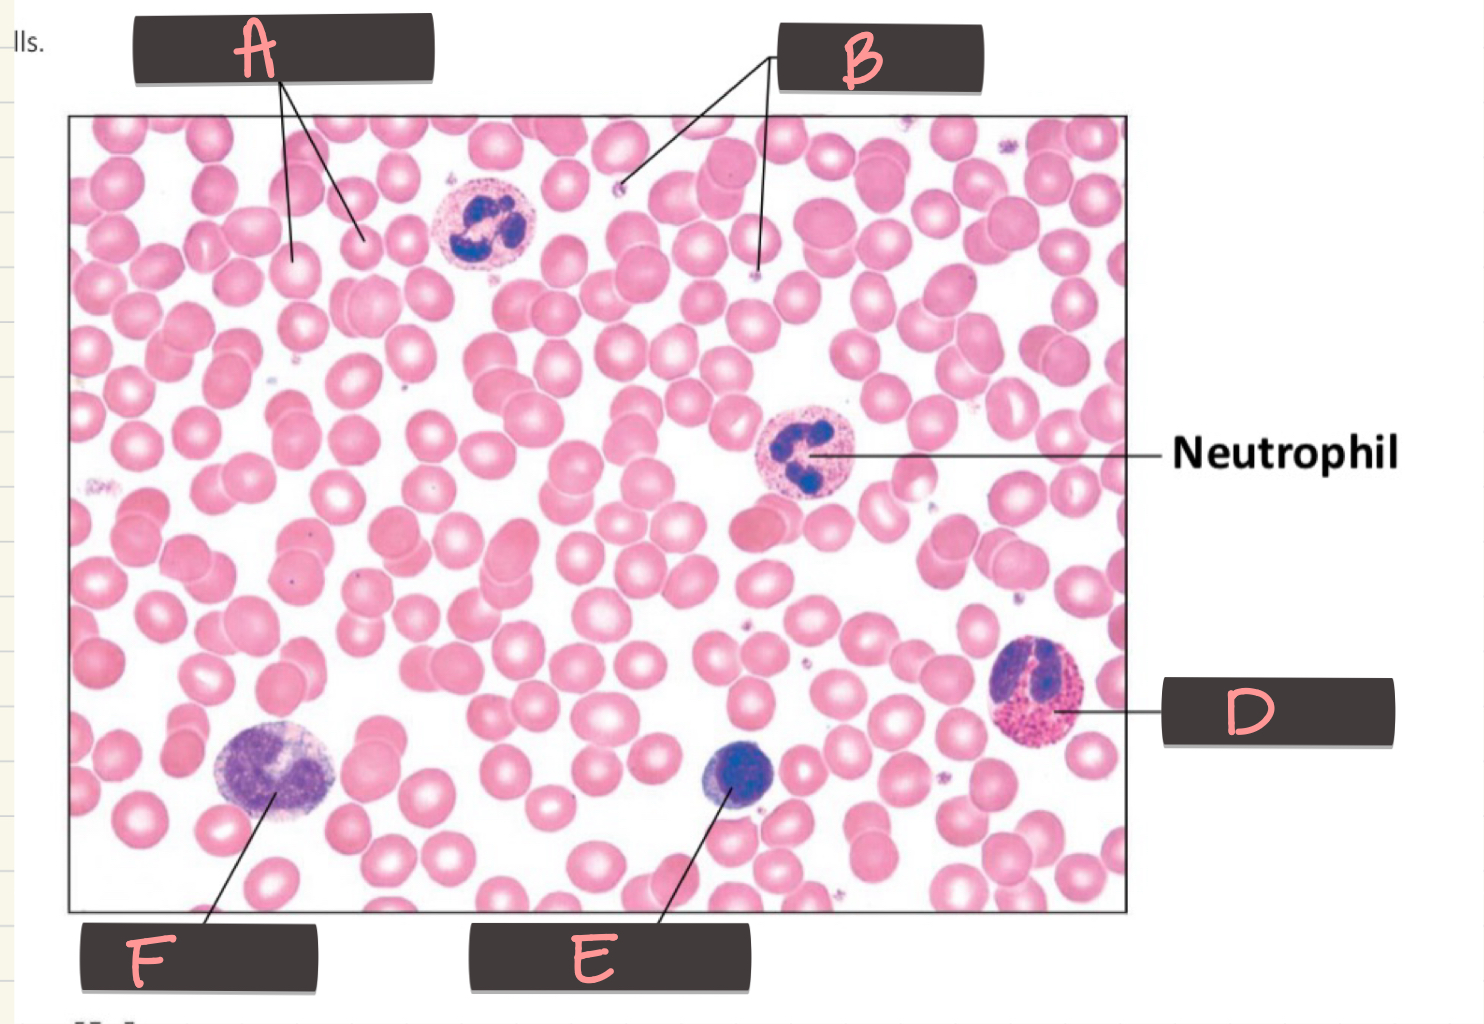
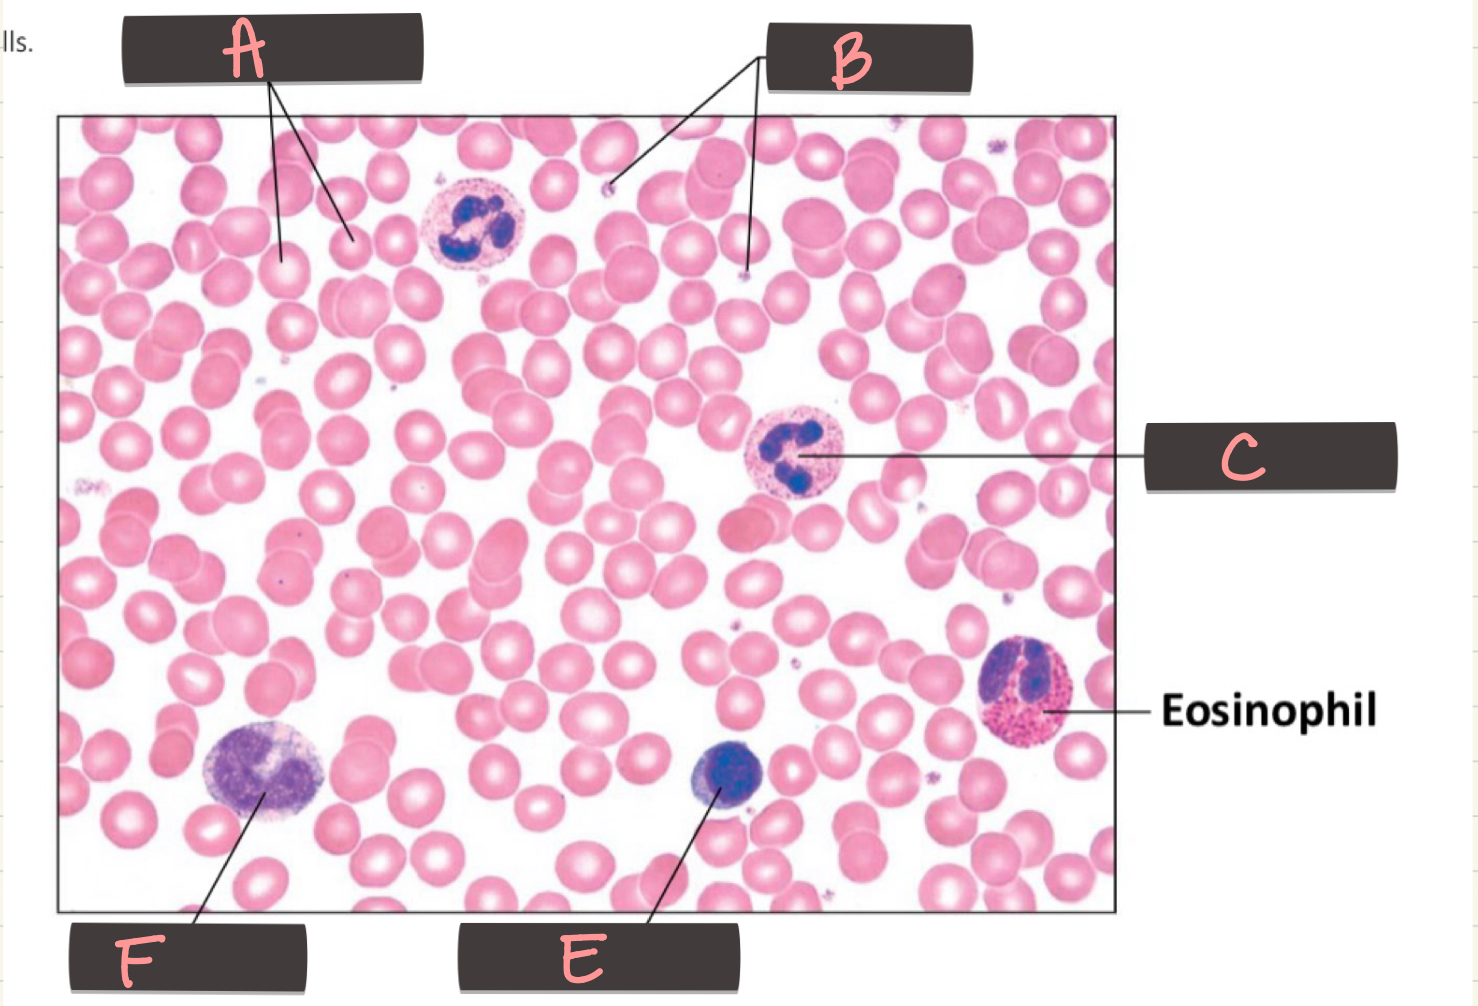
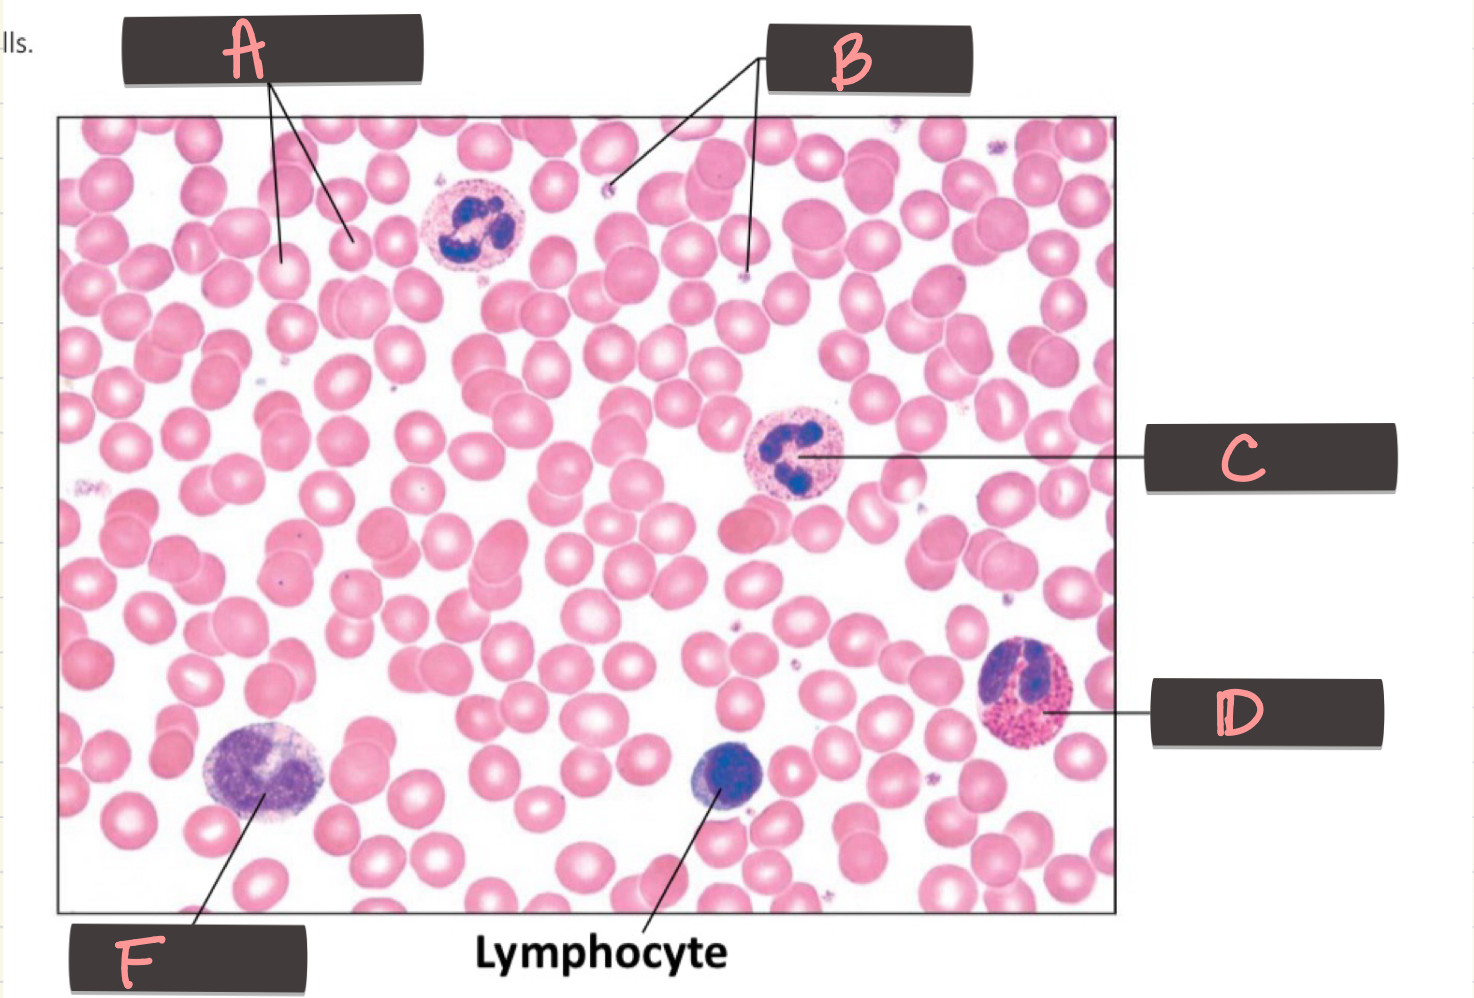
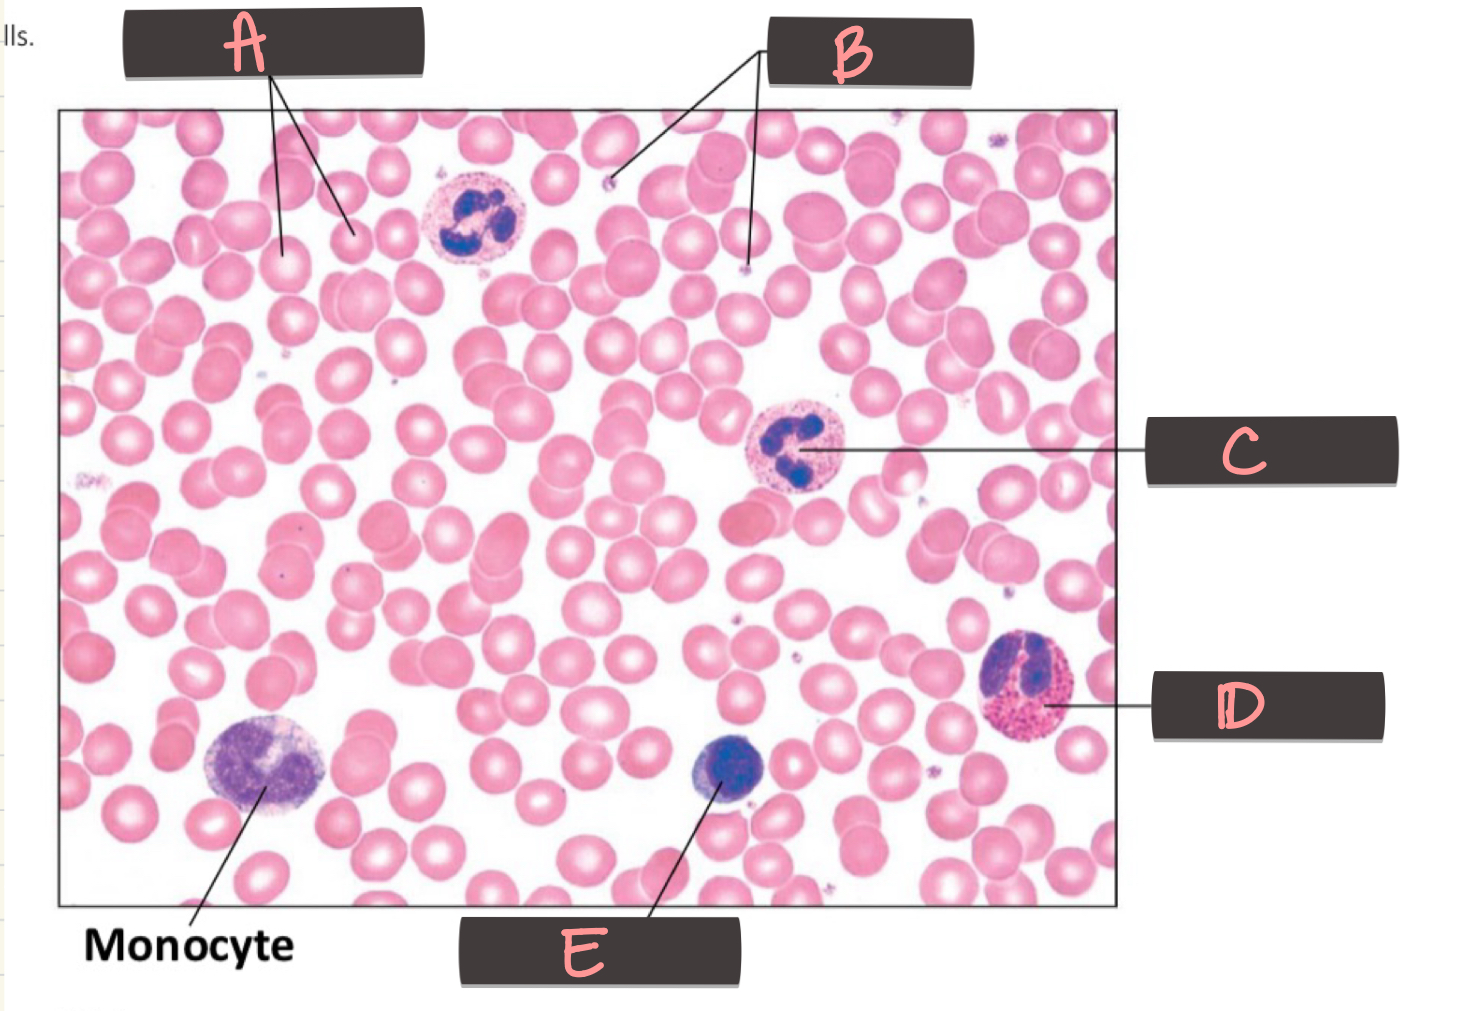
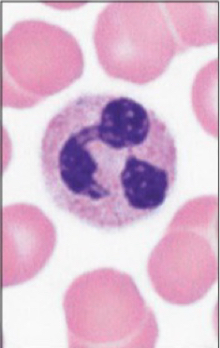

A&P II - WBCs and RBCs
0.0(0)
Card Sorting
1/10
There's no tags or description
Looks like no tags are added yet.
Last updated 2:38 PM on 9/17/25
Name | Mastery | Learn | Test | Matching | Spaced | Call with Kai |
|---|
No analytics yet
Send a link to your students to track their progress
11 Terms
1
New cards
What is located at A?
Erythrocytes
2
New cards

What is located at B?
Platelets
3
New cards

What is located at C?
Neutrophils
4
New cards

What is located at D?
Eosinophil
5
New cards

What is located at E?
Lymphocyte
6
New cards

What is located at F?
Monocyte
7
New cards
Which cell is pictured?
Neutrophil
multilobed, pale cytoplasm
8
New cards

Which cell is pictured?
Eosinophil
bilobed, but use reddish, dark stained cytoplasm to identify
9
New cards

Which cell is pictured?
Basophil
use purplish-black stained granules to identify
10
New cards

What cell is pictured?
Lymphocyte
look for nucleus that takes up almost entire cell
11
New cards

What cell is pictured?
Monocyte
identify by kidney-shaped nucleus